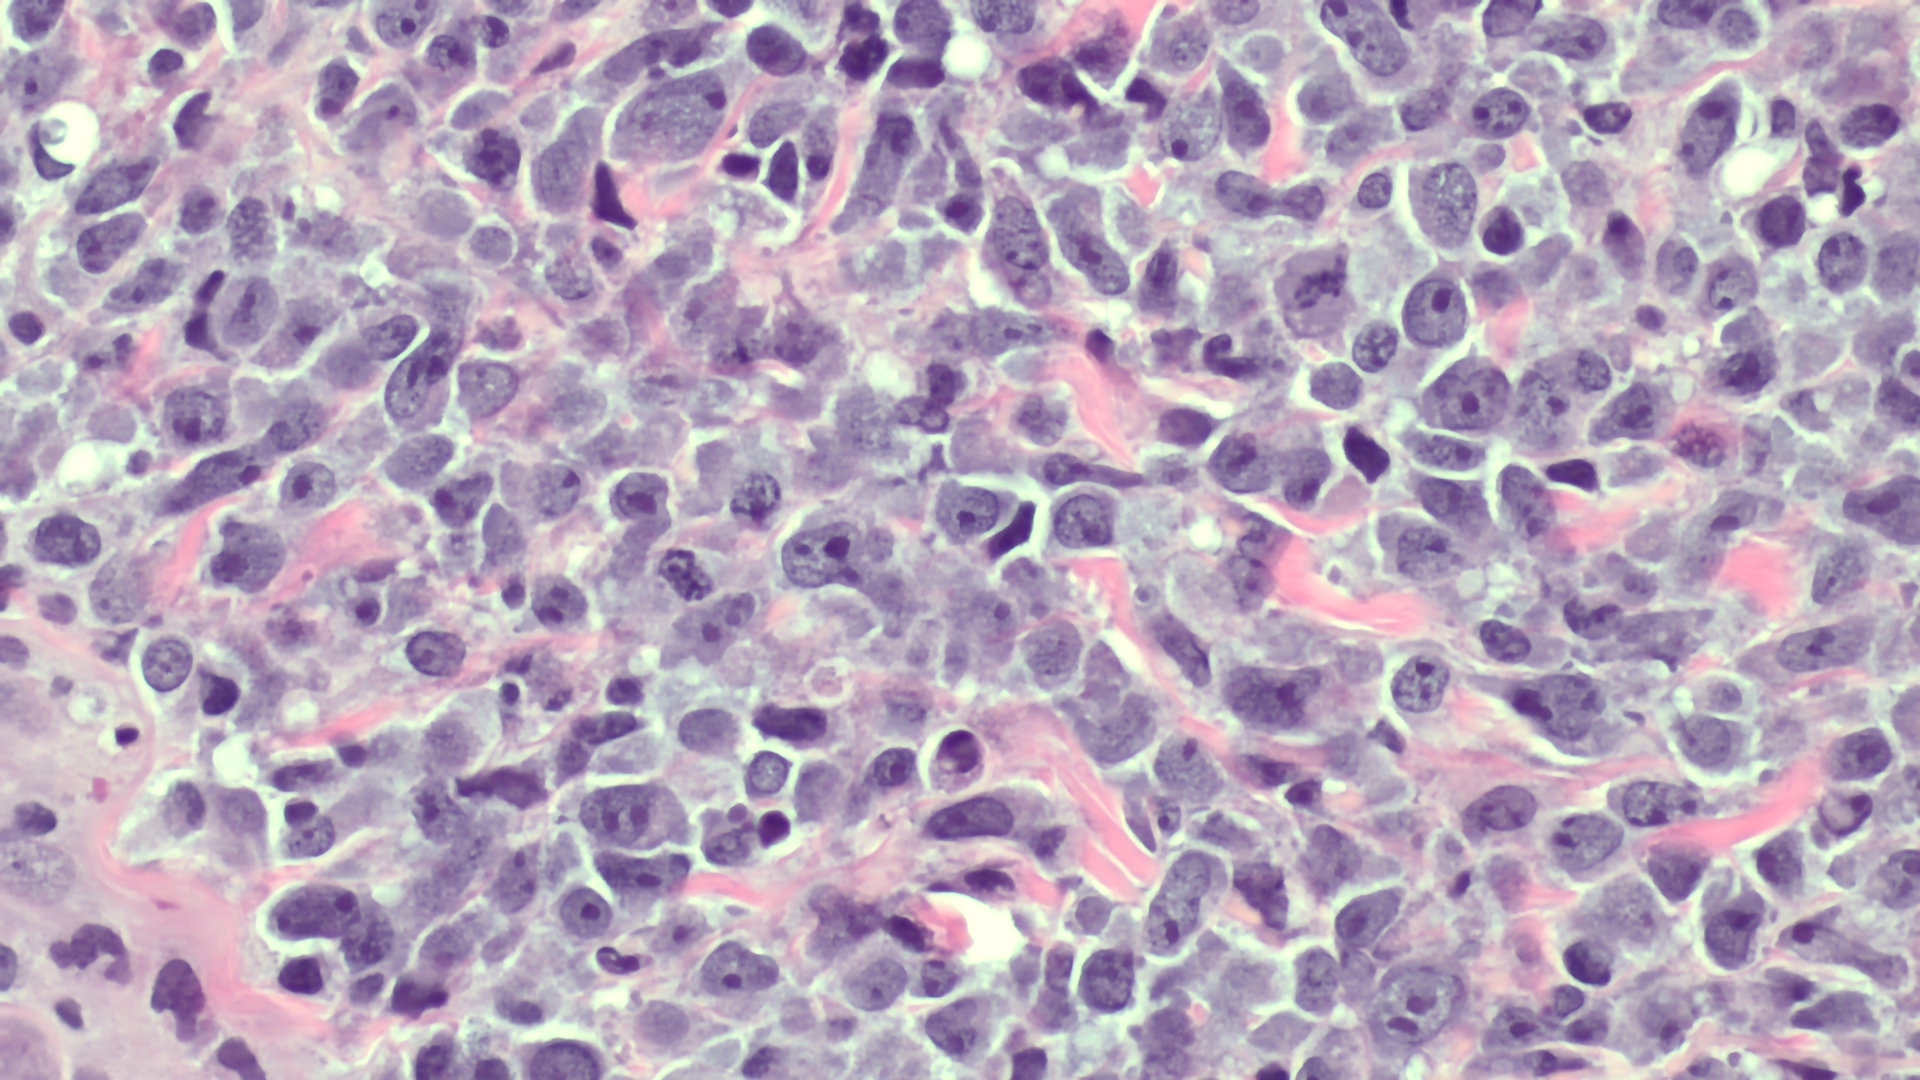

Рецензент
Анапластическая лимфома – это онкозаболевание, при котором злокачественными становятся Т-лимфоциты. Эта онкопатология не является видом рака молочных желез, но злокачественный процесс может развиваться в области груди – у пациентов с имплантами. По медицинской классификации, это один из типов неходжкинской лимфомы.
Как проявляется крупноклеточная лимфома
Крупноклеточная анапластическая лимфома – редкое заболевание. В частности, согласно статистике, в Италии частота BIA – ALCL (анапластической крупноклеточной лимфомы, связанной с грудным имплантом) составляет примерно 3,5 случаев на 100 000 пациентов с имплантами. А во всем мире на 2022 год было зарегистрировано более 1216 случаев. Кроме BIA – ALCL, существуют другие подтипы периферической Т-клеточной лимфомы – типа неходжкинской лимфомы. Это первичная кожная анапластическая лимфома, системная ALK-положительная (ALK +ve) и отрицательная (ALK -ve) анапластические лимфомы.
Причины, особенности течения болезни, ее лечение требует дальнейших многочисленных исследований. Но пока известно, что при анапластической крупноклеточной лимфоме возможны следующие симптомы:
- Развитие поздней серомы, сопровождающейся увеличением размера аугментированной молочной железы, отеком молочной железы, покраснением, болью;
- Появление пальпируемого новообразования в молочной железе, в толще соединительнотканной капсулы вокруг импланта;
- Увеличение лимфатических узлов;
- Повышенная склонность к кровотечениям и образованию синяков;
- Кожный зуд на коже;
- Общая слабость.
При других формах крупноклеточной лимфомы злокачественный процесс локализуется в других участках тела.

Диагностика крупноклеточной лимфомы
Если есть подозрение на лимфому после маммопластики, пациенту необходима консультация маммолога – с осмотром и пальпацией молочных желез, лимфоузлов, тщательным сбором анамнеза, а также инструментальная и лабораторная диагностика:
- УЗИ молочной железы;
- Маммография;
- МРТ молочных желез;
- КТ – для выявления других возможных очагов развития злокачественного процесса в организме;
- Биопсия обнаруженного новообразования для проведения гистологического, иммуногистохимического анализа;
- Биопсия лимфоузлов;
- Общий анализ крови и другие лабораторные исследования;
- Консультация гематолога и некоторых других специалистов узкого профиля.
Лечение анапластической крупноклеточной лимфомы анапластической лимфомы
Агрессивная крупноклеточная лимфома требует быстрого начала лечения и комплексного подхода в борьбе с ней.
- На ранних стадиях развития проводится операция, во время которой удаляется имплант вместе с образованной вокруг него соединительнотканной капсулой (после извлечения она отправляется в лабораторию для проведения анализов). Также проводится лимфодиссекция – удаление пораженных лимфоузлов.
- При распространении злокачественного процесса на лимфоузлы, метастазировании применяется адъювантная химиотерапия, которая обеспечивает системное воздействие на злокачественные клетки с любой локализацией в организме.
- Также может применяться иммунотерапия – лечение моноклональными антителами и ингибиторами иммунных контрольных точек, которые позволяют активизировать естественные защитные противоопухолевые реакции иммунитета.
- На поздних стадиях операция может проводиться с целью паллиативного лечения (циторедукция – для уменьшения объема опухоли). Она дополняется химиотерапией, иммунотерапией и в некоторых случаях – радиотерапией.
Повторная установка импланта после операции не рекомендуется. Реконструкция груди возможна только за счет аутологичных тканей и при отсутствии противопоказаний.
Преимущества нашего центра
Специализированный маммологический центр ежегодно принимает тысячи пациентов не только из Киева, но и со всей Украины. Мы имеем большой и бесценный практический опыт, благодаря которому точно диагностируем не только распространенные виды рака, но и редкие типы онкозаболеваний. Если вы заметили у себя какие-либо симптомы, связанные с молочными железами, и не знаете, какое заболевание это может быть, – обращайтесь к нам. Мы окажем профессиональную помощь в любом случае и при необходимости привлечем специалистов другого профиля для проведения специализированного лечения. Записаться на прием к маммологу в СМЦ можно уже сейчас – с помощью онлайн-формы на этой странице, в чате или по телефону.
Запись на визит в центр
Специалисты по анапластической крупноклеточной лимфоме
Пластический хирург, врач-маммолог, специалист по онкохирургии
более 27 лет стажа
cмотреть профиль и отзывыПластический хирург, врач-маммолог
более 18 лет стажа
cмотреть профиль и отзывыКандидат медицинских наук. Врач-онколог, онкохирург, маммолог
более 19 лет врачебного стажа
cмотреть профиль и отзывыВрач химиотерапевт, клинический онколог
Опыт работы по специальности 7 лет.
Врач второй категории.
Пластический хирург, маммолог, онкохирург, кандидат медицинских наук
Имеет 22 года клинического опыта
cмотреть профиль и отзывы










